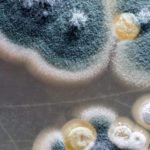

Arquivos
 junho 9, 2021 9:26 am
Publicado por Chicão Barros
junho 9, 2021 9:26 am
Publicado por Chicão Barros
Os trabalhadores informais e inscritos no Cadastro Único para Programas Sociais do Governo Federal (CadÚnico) nascidos em junho podem sacar, a partir desta quarta-feira (9), a segunda parcela do auxílio emergencial 2021. O dinheiro havia sido depositado nas contas poupança digitais da Caixa Econômica Federal em 22 de maio. A terceira parcela poderá ser sacada,... Ver artigo
 junho 9, 2021 9:23 am
Publicado por Chicão Barros
junho 9, 2021 9:23 am
Publicado por Chicão Barros
Uma área abandonada na Rua Gonçalves Dias, entre as Ruas Sete de Setembro e 15 de Novembro, estava em chamas na tarde desta segunda-feira (7). O terreno baldio estava com mato rossado e o fogo aparentemente teria sido colocado para queimar a vegetação que tinha sido retirada. Os Bombeiros foram acionados por moradores próximos e... Ver artigo
 junho 9, 2021 9:14 am
Publicado por Chicão Barros
junho 9, 2021 9:14 am
Publicado por Chicão Barros
A Comissão Parlamentar de Inquérito da Pandemia ouve nesta quarta-feira (9) o depoimento de Antônio Elcio Franco Filho, que foi secretário-executivo do Ministério da Saúde durante a gestão de Eduardo Pazuello. Oficial da reserva do Exército, Franco atualmente é assessor especial do ministro-chefe da Casa Civil, Luiz Eduardo Ramos. A convocação de Elcio Franco foi apresentada pelos senadores Alessandro Vieira (Cidadania-SE), Eduardo Girão (Podemos-CE), Humberto... Ver artigo
 junho 9, 2021 8:16 am
Publicado por Chicão Barros
junho 9, 2021 8:16 am
Publicado por Chicão Barros
Com algumas alterações pontuais, a Prefeitura de Corumbá vai prorrogar por mais uma semana as medidas de restrição temporária adotadas em razão do agravamento da crise de saúde pública provocada pela COVID-19. A decisão foi baseada nos dados apresentados durante reunião do Comitê Extraordinário Covid-19, realizada na manhã desta terça-feira, 08 de junho. “Com o... Ver artigo
 junho 9, 2021 8:10 am
Publicado por Chicão Barros
junho 9, 2021 8:10 am
Publicado por Chicão Barros
Nesta quarta-feira (9) o tempo segue bastante instável em todo Mato Grosso do Sul. Até às 10h tem alerta do Inmet (Instituto Nacional de Meteorologia) para chuvas intensas em grande parte do estado, com possibilidade de chuva moderada à forte, além de raios e rajadas de vento. Corumbá amanheceu com o céu parcialmente nublado e... Ver artigo
 junho 8, 2021 11:17 am
Publicado por Chicão Barros
junho 8, 2021 11:17 am
Publicado por Chicão Barros
Com objetivo de aumentar a participação popular e assegurar a transparência das ações do Poder Público Municipal, a Prefeitura de Corumbá mantém aberto o Orçamento Participativo. O prazo que se encerrava em 31 de maio, foi prorrogado para o dia 30 de junho, quando qualquer munícipe pode sugerir diretrizes para o Plano Plurianual (PPA) 2002/2025.... Ver artigo
 junho 8, 2021 10:50 am
Publicado por Chicão Barros
junho 8, 2021 10:50 am
Publicado por Chicão Barros
É dia de Seleção Brasileira em campo! Nesta terça-feira (8), o Brasil enfrenta o Paraguai pelas Eliminatórias da Copa do Mundo. A bola rola no Defensores del Chaco, em Assunção, às 20h30 (horário de MS). Líder isolada das Eliminatórias, a Seleção Brasileira tem a chance de conquistar uma marca histórica diante do Paraguai. Em caso de vitória sobre a Albirroja, o Brasil... Ver artigo
 junho 8, 2021 10:39 am
Publicado por Chicão Barros
junho 8, 2021 10:39 am
Publicado por Chicão Barros
Os trabalhadores informais e inscritos no Cadastro Único para Programas Sociais do Governo Federal (CadÚnico) nascidos em maio podem sacar, a partir desta terça-feira (8), a segunda parcela do auxílio emergencial 2021. O dinheiro havia sido depositado nas contas poupança digitais da Caixa Econômica Federal em 21 de maio. A terceira parcela poderá ser sacada,... Ver artigo
 junho 8, 2021 9:57 am
Publicado por Chicão Barros
junho 8, 2021 9:57 am
Publicado por Chicão Barros
Marcelo Queiroga, atual ministro da Saúde do governo Bolsonaro depõe hoje (08.jun.2021), pela segunda vez na Comissão Parlamentar de Inquérito da Pandemia. Segundo informações da Agência Senado, esse depoimento foi antecipado por dois fatores, a decisão do Brasil em sediar a Copa América. Presidente da Comissão, em 02 de junho, Omar Aziz (PSD-AM) fez questão... Ver artigo
 junho 8, 2021 9:27 am
Publicado por Chicão Barros
junho 8, 2021 9:27 am
Publicado por Chicão Barros
O início do mês de junho tem sido o mais letal de 2021 em relação aos óbitos relacionados à Covid-19 em Corumbá. O levantamento realizado pela reportagem do Folha MS junto aos boletins epidemiológicos divulgados pelas Secretarias Estadual e Municipal de Saúde, mostram que em apenas cinco dias, a cidade contabiliza 14 mortes. No mês... Ver artigo
 junho 8, 2021 9:24 am
Publicado por Chicão Barros
junho 8, 2021 9:24 am
Publicado por Chicão Barros
Denúncia levou a Polícia Militar (PM) de Maracaju, na região sul do estado, a encerrar uma festa de casamento, a qual ocorria na fazenda na MS 460, na noite do último sábado (5). Na ocasião, havia o show da dupla sertaneja Jads e Jadson e diversos convidados filmaram e postaram nas redes sociais, o que... Ver artigo
 junho 8, 2021 9:03 am
Publicado por Chicão Barros
junho 8, 2021 9:03 am
Publicado por Chicão Barros
A Polícia Federal (PF) prendeu três membros de uma organização criminosa suspeita de promover ataques cibernéticos contra o Supremo Tribunal Federal (STF). A operação foi deflagrada na manhã desta terça-feira (8). As ordens de prisão foram expedidas por determinação do ministro de Alexandre de Moraes. Os agentes da PF cumprem cinco mandados de busca e três de... Ver artigo
 junho 8, 2021 8:59 am
Publicado por Chicão Barros
junho 8, 2021 8:59 am
Publicado por Chicão Barros
O tempo instável vai predominar em MS nesta terça-feira e, até às 9h30, tem alerta do Inmet (Instituto Nacional de Meteorologia) para tempestades com perigo potencial. O calor mais forte está previsto para a região pantaneira. De acordo com os alertas de tempestade do Inmet, em grande parte do Estado existe risco de chuva de moderada... Ver artigo
 junho 7, 2021 3:00 pm
Publicado por Chicão Barros
junho 7, 2021 3:00 pm
Publicado por Chicão Barros
A democrata Kamala Harris faz na Guatemala e no México sua primeira viagem internacional como vice-presidente dos Estados Unidos nesta segunda (7) e terça-feira (8). A visita faz parte dos esforços para tentar conter o fluxo migratório dos países do chamado Triângulo Norte da América Central (Guatemala, El Salvador e Honduras) pela fronteira dos EUA com o México.... Ver artigo
 junho 7, 2021 2:54 pm
Publicado por Chicão Barros
junho 7, 2021 2:54 pm
Publicado por Chicão Barros
Ao contrário do que foi anunciado neste domingo (6), a suspeita de contágio por fungo negro em um paciente diagnosticado com Covid-19 em Corumbá, não foi descartada. Segundo informou o Secretário Municipal de Saúde de Corumbá, Rogério Leite, o resultado preliminar teria dado inconclusivo para a Murcomicose. “Mitologia direta deu inconclusivo eo crescimento em cultura... Ver artigo
 junho 7, 2021 2:42 pm
Publicado por Chicão Barros
junho 7, 2021 2:42 pm
Publicado por Chicão Barros
Na manhã de hoje (7) teve início o II Seminário Estadual da Água que segue até o período da tarde desta segunda-feira. O tema do seminário é “Múltiplas Conexões – Bacias hidrográficas dos rios Paraná e Paraguai”. Além de apresentação do coral da ALEMS e abertura do anfitrião, deputado Renato Câmara (MDB), foi transmitida nesta... Ver artigo
 junho 7, 2021 2:31 pm
Publicado por Chicão Barros
junho 7, 2021 2:31 pm
Publicado por Chicão Barros
O prefeito Marcelo Iunes acompanhou na manhã desta segunda-feira, 07 de junho, a saída equipe do programa Povo das Águas para atendimento aos ribeirinhos residentes na região da parte alta do rio Paraguai e rio São Lourenço. A secretária Municipal de Assistência Social e Cidadania, Amanda Balancieri Iunes, também esteve no embarque. A ação é... Ver artigo
 junho 7, 2021 10:24 am
Publicado por Chicão Barros
junho 7, 2021 10:24 am
Publicado por Chicão Barros
Há vagas para PCD, para nível médio e superior, para atuar em funções administrativas e para atividades de campo. O Grupo Energisa oferece oportunidades de emprego em vários Estados. Há vagas para PCD, para nível médio e superior, para atuar em funções administrativas e para atividades de campo. Interessados podem cadastrar o currículo na nova... Ver artigo